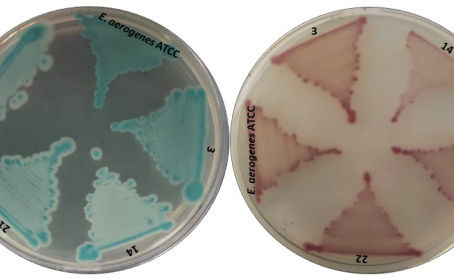
High fluoride resistant bacteria from water samples of Dindigul district, Tamil Nadu, South India

top of page
MOSTLY MICROBES AND INFECTIOUS DISEASES
Welcome to Mostly Microbes and Infectious Diseases. David Ojcius posts newspaper and journal articles in the broad field of microbiology.

Search


Epigenetic reprogramming mechanisms of immunity during influenza A virus infection
#flu #influenza #immunity #immunology This paper reviews #epigenetic mechanisms by which influenza viruses affect cellular gene activity...
David Ojcius
May 16, 20211 min read


Just 2% of SARS-CoV-2−positive individuals carry 90% of the virus circulating in communities
Analyzing data from the Fall 2020 #COVID19 pandemic response at a university in Colorado, US, researchers conclude that just 2% of...
David Ojcius
May 16, 20211 min read


Covid Is Killing Young Children in Brazil, Baffling Doctors
#COVID19 is ravaging Brazil, and, in a disturbing new wrinkle that experts are working to understand, it appears to be killing babies and...
David Ojcius
May 16, 20211 min read


India’s coronavirus crisis spreads to its villages, where health care is hard to find
Rural areas, where >65% of India’s 1.3 billion people live, had been spared in the 1st wave of the #COVID19 pandemic but are now facing...
David Ojcius
May 16, 20211 min read


Involvement of canonical and noncanonical inflammasomes in immune response against oral pathogens
#immunology #oralhealth #innateimmunity #inflammation #inflammasome #dental #dentistry We examined the involvement of the P2 × 7 receptor...
David Ojcius
May 15, 20212 min read


Nathalie Botros, Parvati Iyer, David Ojcius: Does oral health affect severity of COVID-19?
#COVID19 #coronavirus #oralhealth #dental #dentistry Most patients with severe complications from COVID-19 have underlying conditions...
David Ojcius
May 15, 20211 min read


Could targeting immunometabolism be a way to control the burden of COVID-19 infection?
#COVID19 #coronavirus #immunology This review portrays the metabolic consequences of Covid-19 infection at different stages of the...
David Ojcius
May 15, 20211 min read


Coronavirus variants are spreading in India — what scientists know so far
#Coronavirus variants including #B1617 have been linked to India’s surge in infections. Article in Nature describes what we know so far...
David Ojcius
May 15, 20211 min read


Neither B cell nor T cell: The unique group of innate lymphoid cells
by Jean Kanellopoulos and David Ojcius #immunology #ILC #innateimmunity #immunity This free special issue contains 4 review articles that...
David Ojcius
May 15, 20211 min read


New Species Fills Billion-Year Gap in Evolution of Cyanobacteria
#microbiology #evolution Researchers have isolated a new species of #cyanobacteria from a tropical hornwort plant found in Panama. The...
David Ojcius
May 14, 20211 min read


First Genetically Modified Mosquitoes Released in US Are Hatching Now
#Zika #dengue #chikungunya #yellowfever #climatechange As Aedes aegypti #mosquitoes increase their range because of warming #climate,...
David Ojcius
May 14, 20211 min read


India’s Crisis Marks a New Phase in the Pandemic
#India #IndiaCrisis #coronavirus India’s Crisis Marks a New Phase in the #COVID19 Pandemic. In countries where the storm is lifting, it’s...
David Ojcius
May 13, 20211 min read


Piles of ancient poop reveal ‘extinction event’ in human gut bacteria
#microbiota #microbiome Every meal you eat is digested with the help of the bountiful bacteria thronging your intestines. When you're...
David Ojcius
May 13, 20211 min read


US CDC Says Vaccinated People Can Go Maskless in Most Places
Americans who are fully vaccinated against the #COVID19 may stop wearing #Masks or maintaining #SocialDistancing in most settings. In a...
David Ojcius
May 13, 20211 min read


US CDC says fully vaccinated Americans no longer need masks indoors or outdoors in most cases
#COVID19 #coronavirus The US CDC says fully vaccinated Americans no longer need masks indoors or outdoors in most cases. The guidelines...
David Ojcius
May 13, 20211 min read


Salivary biomarkers for the diagnosis and monitoring of neurological diseases
#saliva #dementia #metabolomics #genomics #proteomics Current research efforts on neurological diseases are focused on identifying novel...
David Ojcius
May 12, 20211 min read


“I just need to go ahead and accept it: Boca Juniors is a good soccer team.”
#BocaJuniors A bit of humor: “I just need to go ahead and accept it: Boca Juniors is a good soccer team.”
David Ojcius
May 12, 20211 min read


Mice with severe COVID symptoms could speed vaccine effort
Scientists have developed a strain of #SARSCoV2 #coronavirus that causes severe #COVID19 symptoms in mice. The model could accelerate...
David Ojcius
May 12, 20211 min read


Multi-functional bioactive secondary metabolites from endophytic fungi of marine algal origin
Endophytic fungi from marine macroalgae are endowed with various pharmacologically active metabolites. This study mined, identified and...
David Ojcius
May 12, 20211 min read

High fluoride resistant bacteria from water samples of Dindigul district, Tamil Nadu, South India
Fluoride (F−) pollution is one of the major issues in India and worldwide. Water samples were collected, and analyse the physicochemical...
David Ojcius
May 12, 20211 min read
Home: Blog2
Home: Subscribe

Home: Contact
bottom of page






